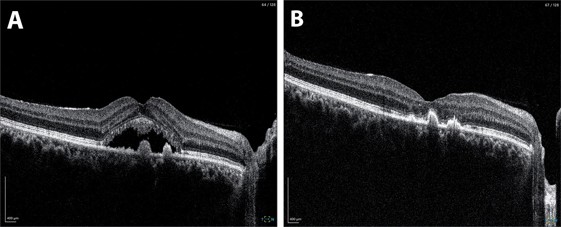

Navigated subthreshold laser in chronic CSCR
Central serous chorioretinopathy (CSCR), characterised by serous detachment of the neurosensory retina and detachments of an altered retinal pigment epithelium (RPE), can be frustrating for both patients and clinicians1. While many acute cases resolve spontaneously, this chronic chorioretinal disorder presents a different challenge, since it can resist conventional treatments and leave patients facing permanent vision impairment2. This case illustrates how innovative laser technology can offer hope when conventional approaches fail.

Fig 1A. An OCT thickness map is imported to the Navilas system and automatically registered and overlaid onto to a live fundus image. B. Treatment planning is done on a touch screen and laser treatment is delivered using real-time eye-tracking. Areas of the fundus, in this case the optic nerve, can be marked as no-go areas for the laser. A titration spot at the arcade is used to calculate an appropriate subthreshold power setting. C. At the end of laser treatment, an image is captured and a summary documenting areas of threshold (laser uptake visible) and subthreshold (no visible uptake) areas of treatment is produced
A persistent problem
A 40-year-old male had been battling CSCR in his right eye for over three years. Despite treatment from both public and private ophthalmologists, which included focal threshold laser photocoagulation and photodynamic therapy (PDT), his condition remained resistant to intervention. Repeat fundus fluorescein angiography revealed two distinct focal leaks: one juxtafoveal and one more distant. His treating ophthalmologist recommended a second round of PDT, but the patient wasn't ready to accept this as his only option.
The clinical picture
Taking the initiative himself, the patient contacted ophthalmology practices across New Zealand, specifically seeking subthreshold laser treatment. His own research had led him to believe this approach might offer benefits over conventional treatments. Following a colleague's referral and preliminary email discussion, he travelled for consultation and potential same-day treatment.
Examination revealed visual acuity of 6/9 in the affected eye, with OCT confirming persistent subretinal fluid. Autofluorescence imaging showed only minimal scarring from previous laser treatment with no evidence of RPE atrophy at the fovea. OCT-angiography ruled out secondary choroidal neovascularisation.
The minimal scarring from previous laser treatment suggested potential under-treatment of the distant leak, while the untreated juxtafoveal leak presented the classic management dilemma of balancing treatment effectiveness against safety.
A tailored approach
Given the chronicity and treatment resistance, a combined strategy using the Navilas navigated laser system was employed. This laser platform provides real-time eye tracking and precise treatment planning using a touchscreen interface3.
The treatment protocol involved threshold laser photocoagulation to the previously treated distant leak where minimal scarring suggested room for additional treatment, combined with subthreshold laser photocoagulation applied to the entire area of subretinal fluid, including both leak sites. The subthreshold approach was particularly crucial for the juxtafoveal leak, where conventional threshold treatment would carry unacceptable risks.
Fig 2. A. At baseline, OCT through the right fovea demonstrates subretinal fluid with small hyper-reflective pigment epithelial detachments. B. Following laser, there has been complete resolution of subretinal fluid at the fovea.
Understanding subthreshold mechanisms
Subthreshold laser represents a paradigm shift in retinal photocoagulation. Rather than creating visible tissue damage, it delivers energy below the threshold for observable retinal changes, using duty cycle modulation to release energy in short pulses that allow tissue cooling between each pulse.
This approach enables selective RPE targeting while preserving overlying photoreceptors. In CSCR, therapeutic benefits likely stem from enhanced RPE metabolic activity and fluid transport capacity, restoration of tight junction integrity and modulation of growth factor expression through heat shock protein pathways.
The precision offered by navigated laser systems proves particularly valuable for subthreshold treatments requiring confluent patterns. Real-time fundus tracking compensates for eye movements, while pre-planned treatment patterns ensure consistent spot placement. Digital integration allows precise correlation between multimodal imaging findings and treatment areas, making previously risky juxtafoveal treatments feasible.
Results and follow-up
The results were notable from an anatomical standpoint. At two-month follow-up, OCT demonstrated complete resolution of subretinal fluid, while autofluorescence imaging confirmed preservation of RPE integrity at the fovea with no treatment-related damage.
However, functional outcomes were more complex. Despite excellent anatomical resolution, the patient reported minimal subjective visual improvement, with visual acuity remaining stable at 6/9. This likely reflects chronic photoreceptor changes from prolonged fluid accumulation, highlighting the importance of early intervention in CSCR.
Interestingly, the patient expressed significant satisfaction with the anatomical resolution. Since one of his main concerns had been progressive photoreceptor atrophy from persistent subretinal fluid, achieving complete fluid resolution provided considerable psychological benefit. He was discharged to a local ophthalmologist and at his most recent follow-up (over six months post-treatment), there has been no recurrence.
Clinical lessons

Fig 3. A. At baseline, fundus autofluorescence images shows the extent of subretinal fluid as demarcated by hyperautofluorescence. B. Following laser, there is reduced hyperautofluorescence without any new areas of laser-induced changes, with the exception of a single titration laser spot at the superior arcade. Extent of residual changes reflect the chronicity of the oedema and helps explain the limited functional improvement
This case highlights several important principles. Chronic CSCR can be remarkably refractory to conventional treatments, including half-dose PDT. While half-dose PDT remains the gold-standard treatment for CSCR4, it carries risks of choroidal infarction and RPE atrophy that may result in worse outcomes than alternative approaches5. The combination of threshold treatment to undertreated areas with subthreshold treatment to the broader affected zone represents a nuanced approach that maximises therapeutic benefit while minimising collateral damage. The discordance between anatomical success and limited functional improvement underscores why early intervention remains crucial.
This case also demonstrates that subthreshold navigated laser photocoagulation represents a valuable addition to our therapeutic options for chronic CSCR, particularly in cases with juxtafoveal involvement or previous treatment failures. The precision offered by navigated systems makes it possible to treat areas previously considered too risky for conventional laser therapy. As we continue to refine our understanding of CSCR pathophysiology, tailored approaches combining different laser strategies may prove increasingly valuable for managing challenging cases. Excellent outcomes can be achieved even when conventional approaches have failed.
Finally, this case also highlights the value of patient engagement and the importance of maintaining hope in the face of treatment-resistant disease.
References
1. Daruich A, Matet A, Dirani A, et al. Central serous chorioretinopathy: Recent findings and new physiopathology hypothesis. Prog Retin Eye Res. 2015;48:82-118.
2. van Rijssen TJ, van Dijk EHC, Yzer S, et al. Central serous chorioretinopathy: Towards an evidence-based treatment guideline. Prog Retin Eye Res. 2019;73:100770.
3. Kernt M, Cheuteu RE, Vounotrypidis E, et al. Focal and panretinal photocoagulation with a navigated laser (Navilas). Acta Ophthalmol. 2011;89(8):e662-664.
4. Dijk EHC van, Fauser S, Breukink MB, Blanco-Garavito R, Groenewoud JMM, Keunen JEE, et al. Half-Dose Photodynamic Therapy versus High-Density Subthreshold Micropulse Laser Treatment in Patients with Chronic Central Serous Chorioretinopathy: The PLACE Trial. Ophthalmology. 2018 Oct 1;125(10):1547–55.
5. Klais CM, Ober MD, Freund KB, Ginsburg LH, Luckie A, Mauget-Faÿsse M, et al. Choroidal Infarction Following Photodynamic Therapy With Verteporfin. Archives of Ophthalmology. 2005 Aug 1;123(8):1149–53
Dr James Leong is an ophthalmologist with expertise in medical retina, uveitis and refractive cataract surgery. He is a consultant at The Eye Clinic, Wellington, and via Te Whatu Ora at Wellington and Hutt Hospitals.


























